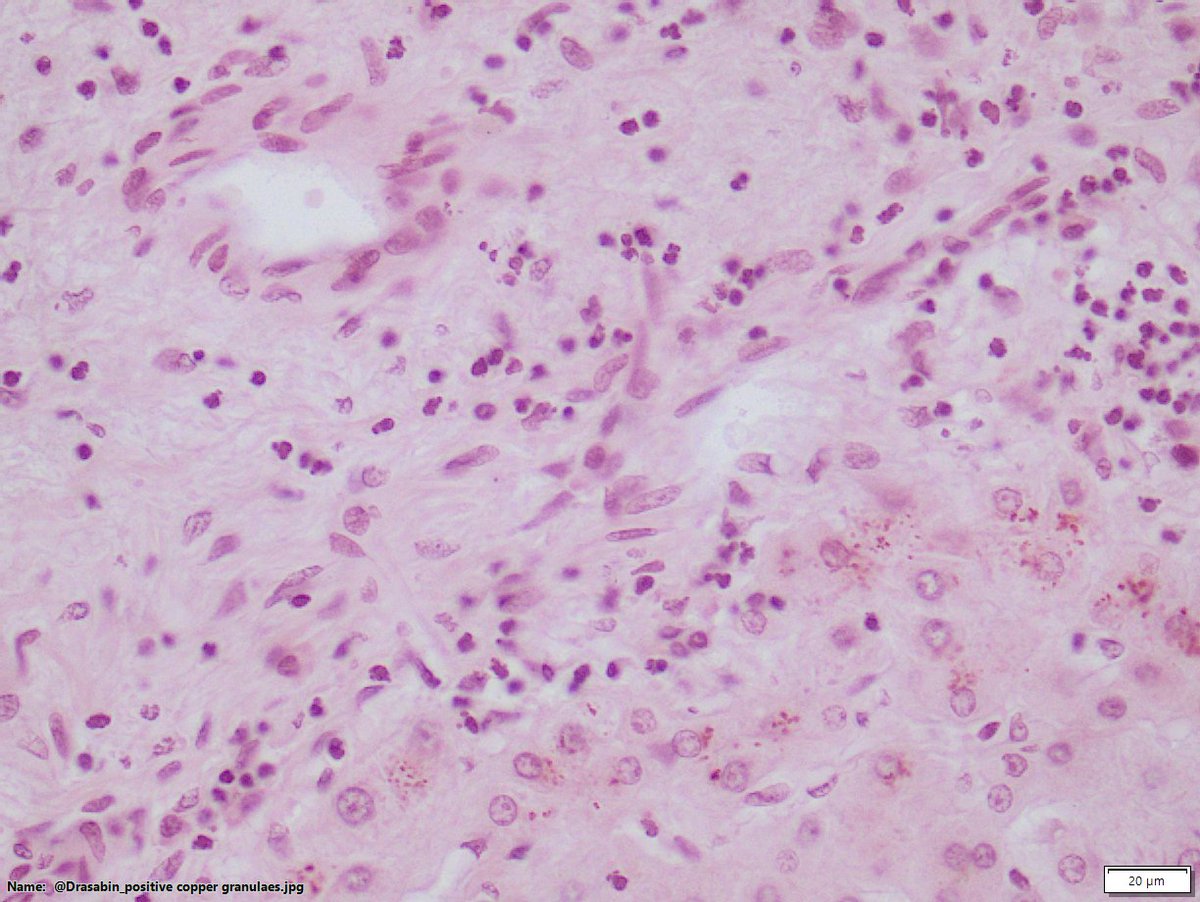
DraSabin's tweet image. Ductopenic patient. Chronic cholestasis. See copper granules both with orcein vs rodanine. Which onedo you prefer? Do you ask both? . #liverpath #cholangitis #cholestasis #pathology

#cholangitis search results
Acute #cholangitis. #Endoscopic view shows spontaneous #pus outflow from the major #papilla together with #biliary #stones

When it rains, it pours. While I'm almost going into my fifth year battling #LongCovid, my 13-year-old dog has been diagnosed with #pancreatitis (his SPEC-cPL was 469, echo shows #cholangitis and sludge in the gallbladder). It seems we're both officially on the chronic illness…

Dilation of the intrahepatic and extrahepatic bile ducts secondary to stone obstruction, diagnosed with POCUS in a patient with fever in the ICU, requiring ERCP and placement of a biliary stent. #POCUS #cholangitis #ICU
Join experts @KowdleyMd, @AutoImmuneLiver, and Marlyn J. Mayo, MD as they share data 📊 on emerging targeted Primary biliary #cholangitis treatments. 📅 November 10, 2023 🏆 Earn 1.5 CME Credits 🔗 ms.spr.ly/60119FXzv
THIS WEEK: Join experts @KowdleyMd, @AutoImmuneLiver, and Marlyn J. Mayo, MD as they share data 📊 on emerging targeted Primary biliary #cholangitis treatments. 📅 November 10, 2023 🏆 Earn 1.5 CME Credits 🔗 ms.spr.ly/60199hTEU #AASLD
🔴Sphincteroplasty upto 15mm is good strategy to achieve full ductal clearance.This case referred for spyglass;CRE Dilatation 12mm successfully made the duct cleaned. @Almotasembilla1 @AlmuhaidbAymen @CarlKayMD @SyedGerdezi @DrSalihTokmak @drkeithsiau #ERC #Teaching #Cholangitis



Prospective assessment of clinical criteria for diagnosis and severity of acute #cholangitis ow.ly/6klP50MPGIw

#Cholangitis and #itch—two symptoms that can significantly impact the lives of people with #PSC. Drs Thorburn and Hussain joined us to discuss these challenges and answer your questions. You can now watch (or re-watch) the full session. ➡️ buff.ly/ZPb011t #LetsBeatPSC
🚨 TODAY: Join experts @KowdleyMd, @AutoImmuneLiver, and Marlyn J. Mayo, MD as they share data 📊 on emerging targeted Primary biliary #cholangitis treatments. 📅 November 10, 2023 🏆 Earn 1.5 CME Credits 🔗 ms.spr.ly/60149hTRI
Episode 3 Now Available! Patient Voices in Primary Biliary Cholangitis: A CE Podcast Series to Recognize Challenges, Reduce Disparities, and Improve Outcomes Follow the link in our bio to earn FREE AMA, ABS, ANCC or ACPE credit! #PBC #LiverDisease #Cholangitis #PracticePointCME…

Primary #sclerosing #cholangitis, also called primary #biliary cholangitis, is such a pain. It is difficult to diagnose, and most #doctors do not have a clue. It is an #autoimmune disorder.

Ductopenic patient. Chronic cholestasis. See copper granules both with orcein vs rodanine. Which onedo you prefer? Do you ask both? . #liverpath #cholangitis #cholestasis #pathology



🟪NEW Article in press❕ Loss of biochemical response at any time worsens outcomes in UDCA-treated patients with primary biliary #cholangitis 🔓#OpenAccess at 👉jhep-reports.eu/article/S2589-… #LiverTwitter

Recognize the signs of cholangitis early! Symptoms include upper right abdomen pain, fever, chills, loss of appetite, and jaundice. Don’t ignore these warning signs—seek expert care. #Cholangitis #LiverHealth #JaundiceAwareness #SRMGlobalHospitals #ExpertCare

❕A home-based exercise programme attenuates fatigue in primary biliary cholangitis: Results from the EXCITED clinical trial 🔓#OpenAccess at👉jhep-reports.eu/article/S2589-… #LiverTwitter #Cholangitis @CholestasisDoc

#MedNews - The FXR agonist #cilofexor does not slow down fibrosis progression in patients with noncirrhotic primary sclerosing #cholangitis. Full story 👉 buff.ly/M1UlDS6 #GastroTwitter
From #UEGWeek 2025 - Treatment with #linerixibat significantly and rapidly reduces itch in people with primary biliary #cholangitis. Full story 👉 buff.ly/Y5BmDMx #MedNews
The DDC model is a key tool for studying cholangitis and PSC. It allows assessment across endpoints such as bile duct proliferation, fibrosis, and inflammation, providing broad insight into drug effects. #PSC #Cholangitis #LiverDisease #Preclinical #CRO smccro-lab.com/contact/
smccro-lab.com
Contact | Service Inquiries | SMC Laboratories Inc.
Contact us through this form. SMC Laboratories offers drug efficacy evaluation studies and histopathological analysis services using disease model animals.
#BTCs are notorious for infectious complications like #cholangitis. Interesting paper reviewing the negative impact of antibiotic therapy in patients with cholangiocarcinoma treated with chemoimmunotherapy karger.com/ocl/article-ab… @curecc @CCA_Alliance @GIcancerDoc @ArndtVogel
#cholangitis #acutecholangitis #tokyoguidelines #gallbladder #cbd Acute Cholangitis Management – Tokyo Guidelines 18: A tale of forgotten CBD stent, post ERCP. youtu.be/G6S4mOw52R0?si…
youtube.com
YouTube
Acute Cholangitis Management 2025 (HDTS) | Tokyo Guidelines 18,...
Cholangitis is a life-threatening bile duct infection. Watch for signs like fever, jaundice, dark urine, & abdominal pain. Learn more 👉 sparshdiagnostica.com/cholangitis/ #Cholangitis #LiverHealth #BhaloTheko

📢 New Research Published by #Gastroenterology Research! Impact of Hospital Teaching Status on Outcomes of #Acute #Cholangitis: A Propensity-Matched Analysis of #Hospitalizations in the #United #States gr.elmerpub.com/index.php/gr/a…


In this recent @SciReports article, scientists identified distinct subpopulations of #endothelial cells and elucidated their potential roles in primary biliary #cholangitis development and therapeutic response. 💡 Learn more: go.nature.com/45YTe6t

Die Therapieoptionen bei primär biliärer #Cholangitis waren bislang limitiert – vor allem für Betroffene, die auf UDCA unzureichend ansprechen. #Seladelpar von @GileadSciences kann diese Lücke jetzt schließen. #galenus2025-Kandidat springermedizin.de/seladelpar-cho…
Presence of small and multiple gallstones increases the risk of biliary complications doi.org/10.18528/ijgii… #Cholangitis #Gallstones #Jaundice #obstructive #Pancreatitis

#Elafibranor (Iqirvo) von Ipsen Pharma ist eine neue #Zweitlinientherapie der primär biliären #Cholangitis (PBC). In der Zulassungsstudie sprachen mehr als 50 Prozent der Betroffenen auf die Therapie an. #Galenus2025 aerztezeitung.de/Nachrichten/Iq…
RT @MayoTransplant: This paper examines the use of #AI to augment performance of prediction models in alcoholic #hepatitis and #cholangitis patients. #liverdisease @Dr_Vijay_Shah bit.ly/4lejZYW

This paper examines the use of #AI to augment performance of prediction models in alcoholic #hepatitis and #cholangitis patients. #liverdisease @Dr_Vijay_Shah bit.ly/4k0pw4n

Experiencing sudden, intense pain in your upper right abdomen, coupled with yellowing of the skin and eyes (jaundice), and possibly fever or chills? #Cholangitis #BileDuctInfection #Jaundice #AbdominalPain #LiverEmergency #SeekMedicalHelp #EarlyDiagnosisSavesLives #GutHealth

👤 Michael Trauner. #live Primary sclerosing #cholangitis: current and future medical approaches. Síguenos #endirecto 👉bit.ly/3DJ2z6E

Ductopenic patient. Chronic cholestasis. See copper granules both with orcein vs rodanine. Which onedo you prefer? Do you ask both? . #liverpath #cholangitis #cholestasis #pathology

🌟 @RahulKarnaMD teaching the crowd on non-obstructive recurrent #cholangitis in patients with a surgically altered anatomy 🤒 🌡️ #DDW2025 #BeGutsy

Presence of small and multiple gallstones increases the risk of biliary complications doi.org/10.18528/ijgii… #Cholangitis #Gallstones #Jaundice #obstructive #Pancreatitis

Acute #cholangitis. #Endoscopic view shows spontaneous #pus outflow from the major #papilla together with #biliary #stones

Prospective assessment of clinical criteria for diagnosis and severity of acute #cholangitis ow.ly/6klP50MPGIw

SEPTEMBER ISSUE | #ResearchHighlight PRIMARY SCLEROSING #CHOLANGITIS | Inflammation to cancer in PSC rdcu.be/dkhkB

❕A home-based exercise programme attenuates fatigue in primary biliary cholangitis: Results from the EXCITED clinical trial 🔓#OpenAccess at👉jhep-reports.eu/article/S2589-… #LiverTwitter #Cholangitis @CholestasisDoc

🟪NEW Article in press❕ Loss of biochemical response at any time worsens outcomes in UDCA-treated patients with primary biliary #cholangitis 🔓#OpenAccess at 👉jhep-reports.eu/article/S2589-… #LiverTwitter

❗️Deep learning helps discriminate between autoimmune hepatitis and primary biliary cholangitis 🔓#OpenAccess at👉jhep-reports.eu/article/S2589-… #LiverTwitter #cholangitis #AI 🙏@jnkath et al.

ICYMI: What is the #epidemiology of primary sclerosing #cholangitis? #AGAReadingRoom @AmerGastroAssn #Gastroenterology Read more: bit.ly/46MoBOV

And when the scope reduction is tough, you make it work because during a #cholangitis case, we ain't got time to muck around #GITwitter #MedTwitter #ERCP #interventionalgi #thisiswhatwedo


➡️ Are you optimally monitoring your patients with primary biliary #cholangitis? #MedEd #CME #MedTwitter #EndoTwitter 📝 ms.spr.ly/6015eChjH

Epigenetic Modifications in Generalized Autoimmune Epithelitis: Sjögren’s Syndrome and Primary Biliary Cholangitis by Yves Renaudineau et al. mdpi.com/2075-4655/3/3/… #sjogrensyndrome #cholangitis #epigenetics

ICYMI: How great a concern is primary biliary #cholangitis in the Western world? #AGAReadingRoom @AmerGastroAssn #Gastroenterology Read more: bit.ly/3ceowfW

❕Laminin 511-E8, an autoantigen in IgG4-related cholangitis, contributes to cholangiocyte protection 🔓#OpenAccess at 👉jhep-reports.eu/article/S2589-… #LiverTwitter #cholangitis

❕Fecal deoxycholic acid associates with diet, intestinal microbes, and total bilirubin in primary sclerosing #cholangitis 🔓#OpenAccess at👉jhep-reports.eu/article/S2589-… #LiverTwitter @clbowlus

🟪NEW Article in press❕ Surrogate markers of bile duct disease progression in primary sclerosing #cholangitis – A prospective study with repeated ERCP examinations 🔓#OpenAccess at 👉 jhep-reports.eu/article/S2589-… #LiverTwitter

.@CymaBay Announces @US_FDA Acceptance of NDA and Priority Review for #Seladelpar for the Treatment of Primary Biliary #Cholangitis #PBC - ow.ly/vuPI50QACmu #rarediseases #orphandrugs

#PrecisionMedicine 🤩Newly_Published_Article "Risk Factors for Recurrence of Primary Sclerosing #Cholangitis after #Liver_Transplantation: Single-Center Data" 👨🔬 Elisa Catanzaro et al. @elisasacat 👉mdpi.com/2683712 @MDPIOpenAccess @MediPharma_MDPI

Episode 3 Now Available! Patient Voices in Primary Biliary Cholangitis: A CE Podcast Series to Recognize Challenges, Reduce Disparities, and Improve Outcomes Follow the link in our bio to earn FREE AMA, ABS, ANCC or ACPE credit! #PBC #LiverDisease #Cholangitis #PracticePointCME…

Look at our latest abstract. Explore the intricate connections between these conditions through innovative research. ow.ly/UAQJ50PWByN #MedicalResearch #IBD #Cholangitis #AbstractInsights #StayInformed

Cholangitis is inflammation of bile duct system.The bile duct system carries bile from the liver and gallbladder to the first part of your small intestine. In most cases cholangitis is caused by a bacterial infection. Follow #icarebilling for more updates #HealthCare #Cholangitis

In this recent @SciReports article, scientists identified distinct subpopulations of #endothelial cells and elucidated their potential roles in primary biliary #cholangitis development and therapeutic response. 💡 Learn more: go.nature.com/45YTe6t

Something went wrong.
Something went wrong.
United States Trends
- 1. Good Friday 43.1K posts
- 2. #LingOrm_DiorMacau4Seasons 203K posts
- 3. #GenshinSpecialProgram 11.8K posts
- 4. Josh Allen 41.4K posts
- 5. Four Seasons 11.5K posts
- 6. Texans 60.8K posts
- 7. #FridayVibes 3,155 posts
- 8. #FridayMotivation 2,171 posts
- 9. #GenshinImpact 60.2K posts
- 10. Bills 150K posts
- 11. Niger 53.2K posts
- 12. Openmind 50.3K posts
- 13. Joe Brady 5,352 posts
- 14. Beane 3,006 posts
- 15. Infinit 82.5K posts
- 16. Davis Mills 9,074 posts
- 17. Traitor 114K posts
- 18. McDermott 4,889 posts
- 19. Miden 13K posts
- 20. Commander in Chief 82.5K posts











































